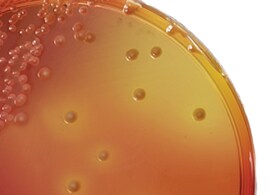
USP-60-Culture-Media-Burkholderia-cepacia-270x195px USP-60-Culture-Media-Burkholderia-cepacia-270x195px

Search
Search
Thermo Scientific™ 微生物解决方案为解决制药和生物技术工业的独特需求而设计。我们为制药微生物学实验室提供了一系列经验证的解决方案,支持无菌药物、疫苗和生物技术产品的生产和质量保证。
我们认为患者的安全是最重要的,确保法规合规性无可争议。我们致力于为制药微生物学提供更多服务,从原材料到成品,从环境监控到微生物鉴定以及培养基灌装,您可以信任我们产品的专业品质。
通过洋葱伯克霍尔德菌复合物未灭菌微生物检查试验,简化您的实验室工作流程。
全面的产品组合涵盖了完整的工作流程要求,适用于所有未灭菌制药洋葱伯克霍尔德菌产品试验要求:成品培养基、干粉培养基和添加剂、质控微生物(包括洋葱伯克霍尔德菌 ATCC BAA-245 和多嗜伯克霍尔德菌 ATCC BAA-247)以及全系列诊断产品。
Thermo Scientific™培养基由我们自己的生物提取物配置生产,保持着高质量标准。作为动物源蛋白胨和植物源 Veggietones™ 的原始生产商,我们全面监控从开始到结束的生产过程。因此您可放心,您所使用的培养基都已在质量和一致性上经过严格的检测
Thermo Scientific 的成品培养基品种繁多,符合各项监管要求,值得信赖。我们提供一系列专门设计的配方,符合美国、欧盟和日本药典的相关要求,并符合 FDA 和 ISO 对生物负载和纯水检测要求。
Thermo Scientific™ 三层包装辐照平板设计用于较严格的管制环境,拥有较新的质量保障技术。从先进的层级保护到增强的性能,它是环境监测的较佳选择。
使用放置在生物工艺容器 (BPC) 中的 Thermo Scientific 成品培养基进行无菌生产过程的验证,可避免延误并减少验证中存在的污染风险。这种即用型液体培养基,含有经过验证的和合规的无动物源成分 (ADCF) 和胰蛋白胨大豆肉汤,无需混合以及无菌化处理。只需简单地连接,生物工艺容器就可完成之后的工作。
确保对制药材料进行微生物定量质控检测的一致性。Thermo Scientific™ 质控微生物保存在凝胶中,易于再水化,减少污染的风险
Quanti-Cult™ 双瓶系统,提供 ATCC® 衍生*微生物的完整溯源信息,并可用您自己的设备进行自定义环境分离,以用于促生长测试。
实验室一直在寻找减少费用而不降低质量的新方法。这就是为什么我们的微生物组合产品提供了许多高性价比的方法帮您实现目标,包括 Thermo Scientific™ RapID™系统用于广谱微生物手动鉴定的高性价比系统。
确保对药品进行一致的微生物评价,成就有效的高性能产品。使用来自真实、高品质 ATCC®* 培养物的定量质控微生物,在可立即再水化的安全样品瓶中降低污染风险。
相关产品:
了解在制药生产中用于环境监测的沉降碟和表面接触碟,如何成功执行现场校验。了解有关三层包装辐照灭菌板的更多信息。 设计用于大多数受监管环境,使用较新的质保技术。是环境监测的较优选择。
在这一独家网络讲座中,我们将探讨在设计培养基模拟试验方案时需考虑的重要因素,以及这些因素如何用于风险矩阵的建立。您将了解到一次性技术如何使无菌生产流程的验证更加安全、简单。